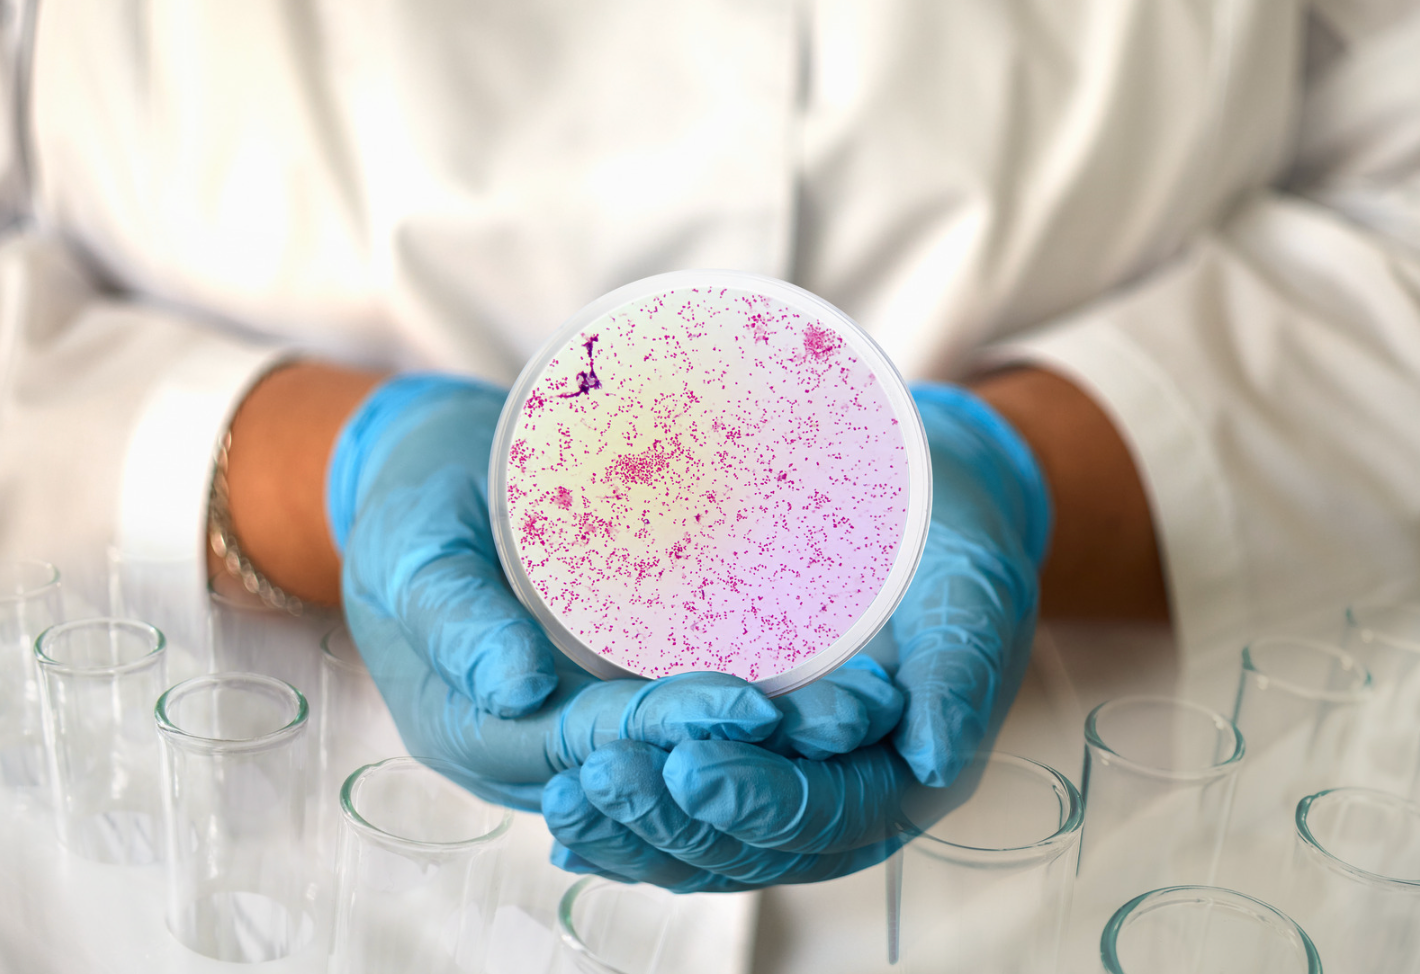
sanity image

Gonoré
Gonoré – Årsaker, symptomer og behandling
Gonorè er en seksuelt overførbar infeksjon forårsaket av bakterien Neisseria gonorrhoeae som lager sykdom i kjønnsorganer, endetarm, hals eller øye. Sykdommen smitter ved ubeskyttet sex. Den kan også smitte fra mor til spedbarn under fødsel. Forekomsten av gonorè i Norge er økende, særlig blant menn som har sex med menn. Gonorè er svært vanlig på verdensbasis og mye av smitten i Norge stammer fra utlandet. Symptomene kan variere og ofte gir den lite eller få symptomer. Derfor sprer bakterien seg lett. Ubehandlet kan gonorè gi infertilitet og er derfor viktig å behandle.
Vi tilbyr nå hjemmetest som kan avdekke både klamydia og gonoré. Bestill hjem og få svar mellom 3-7 virkedager.
Bestill hjemmetest Se ledige timer